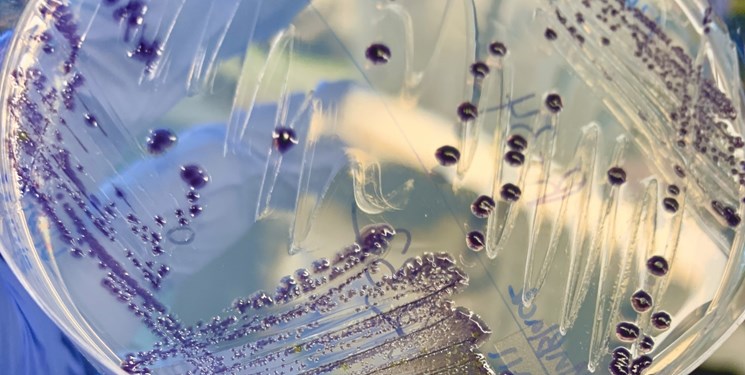

تولید لباسهای فضایی ضدمیکروبی برای فضانوردان
طراحی و تولید لباسهای فضایی ضدمیکروبی میتواند مشکلات مربوط به نیاز به لباسشویی را در میان فضانوردان حل کند.
به گزارش خبرنگار گروه علم و پیشرفت خبرگزاری فارس به نقل از نکست وب، آژانس فضایی اروپا اعلام کرد نسل بعدی کاوشگران ماه با مجموعهای از لباسهای فضایی کاملاً ارتقا یافته تجهیز خواهند شد، زیرا فناوری نساجی از زمان انجام ماموریت های آپولو در دهه های 60 و 70 میلادی بسیار پیشرفت کرده است.
لباسهای فضایی به غیر از اینکه باید در یک محیط فرازمینی با خلاء بالا، در برابر تشعشع، دمای شدید و گرد و غبار فضایی مقاوم باشند، در معرض میکروبهای قدیمی و متنوع نیز قرار دارند.
آژانس مذکور در حال انجام طرحی به نام PExTex برای ارزیابی مواد مناسب برای طراحی و تولید لباس های فضایی آینده است.
انجمن فضایی اتریش که طرحی فرعی به نام BACteRMA را هدایت می کند، به این برنامه ملحق شده که هدف آن یافتن راه هایی برای محدود کردن رشد میکروب در پوشش داخلی لباس فضانوردی است.
به لطف مواد شوینده، ماشین لباسشویی و خشک کن، این کار بر روی کره زمین به اندازه کافی آسان است. اما در زیستگاه های روی ماه یا فراتر از آن، شستن فضای داخلی لباس فضانوردی به طور مداوم ممکن است عملی نباشد.
علاوه بر این، لباسهای فضایی به احتمال زیاد بین فضانوردان مختلف به اشتراک گذاشته میشوند و برای دورههای طولانی استفاده، احتمالاً در شرایط مطلوب برای رشد میکروارگانیسمها آماده میشوند. لذا نیاز به یافتن راه حل های جایگزین برای جلوگیری از رشد میکروبی داشتیم.
محققان مجبور شدند از مواد ضد میکروبی سنتی مانند مس و نقره چشم پوشی کنند، زیرا آنها در طول زمان کدر می شوند. محققان سپس به آنچه متابولیت های ثانویه نامیده میشود، روی آوردند.
آنها ترکیبات آلی هستند که توسط گیاهان، قارچها و میکروارگانیسمها تولید میشوند، اما مستقیماً در فرآیندهای سلولی اولیه مورد نیاز برای رشد، نمو و تولید مثل دخالت ندارند. آنها از بدن در برابر پاتوژن ها و سایر ارگانیسم ها حفاظت میکنند که به آنها کیفیت آنتی بیوتیکی می بخشد.
ظاهراً استارتآپ اتریشی که بر روی توسعه رنگهای ارگانیک برای منسوجات با استفاده از میکروبها تمرکز دارد، مجموعهای منحصربهفرد «باکتریشناسی» را در اختیار دارد که تولید لباس های جدید را تسهیل می کند. انتظار می رود نمونه اولیه این پارچه ها تا سال 2024 آماده شوند.
پایان پیام/
https://thenextweb.com/news/antimicrobial-spacesuits-solution-astronaut-laundry-woes

بدون دیدگاه